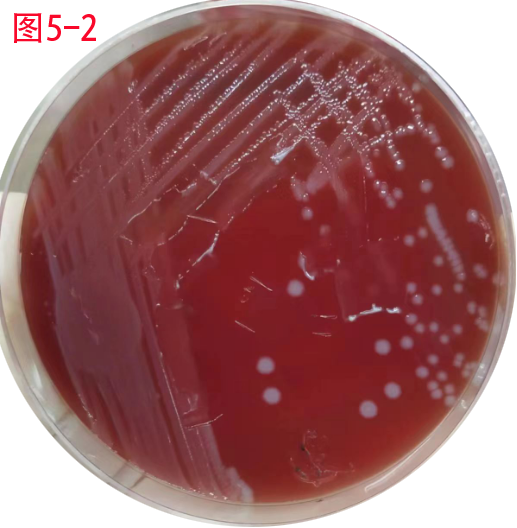

【第一百三十八期】基层检验网形态学培训
【第一百三十八期】基层检验网形态学培训
每周一次,每次几张,只要您坚持来,抽出几分钟的时间,相信您的识图能力会不知不觉的提升哦
1、冉XX 女82岁 主诉:腹痛腹胀8天,血常规检查:WBC:4.82,RBC:1.96 HB:60g/l,PLT:182,大便隐血:阳性;结合病史下图(10*40,未染色)最可能是:
答案:(钩虫卵)
解析:
椭圆形,大小约(57-76)umX(36-40)um。卵壳较薄,无色透明,卵内通常含2~4个卵细胞,卵壳与卵细胞间有明显的空隙。在便秘者粪便内或粪便放置过久时,卵细胞可继续分裂成桑葚状。十二指肠钩口线虫卵和美洲板口线虫卵两种形态相似,不易区别。(人体寄生虫形 人民卫生出版社 第九版 主编 诸欣平 苏川 P169)
2、段XX 男63岁 主诉:左侧腰腹疼痛8小时 尿液常规检查:GLU:-,BLD:3+,LEU:-,PRO:-,NIT:-,URO:-,BIL:-,KET:+-,PH:5.00,SG:1.025,颜色:淡黄色,浊度:微浑;红细胞计数:579/ul,白细胞计数:7/ul,结晶计数:100/ul,上皮计数:23/ul.;结合病史下图(10*40,未染色)最可能是:

答案:(尿酸结晶)
解析:呈黄色、暗棕色、其形状为三棱形、哑铃形、蝴蝶形或不规则形。大量尿酸结晶见于高尿酸肾病及尿酸结石,亦可见于急性痛风症、儿童急性发热、慢性间质性肾炎等。(临床检验基础 人民卫生出版社 第五版 主编 刘成玉 罗春丽 P179)
解析:该类细胞形态特征明显 , Auer 小体易见 , 呈“柴捆状”。急性早幼粒细 胞白血病 (APL) 患者骨髓中常以颗粒增多的异常早幼粒细胞增生为主 。颗粒增多 的异常早幼粒细胞形态特点为胞体大小不 一 , 胞核不规则 , 染色质粗细不等 , 胞 质量丰富 , 含大量密集紫红色嗜天青颗粒 , 无颗粒之外浆呈伪足状突出 。柴捆细胞是 APL 骨髓细胞形态中较典型的形态特征。
3、喻XX 女58岁 主诉:右侧腰痛疼痛1天 尿液常规检查:GLU:-,BLD:1+,LEU:2+,PRO:3+,NIT:-,URO:-,BIL:-,KET:+-,PH:6.50,SG:1.005,颜色:无色,浊度:清亮;红细胞计数:0/ul,白细胞计数:256/ul,结晶计数:100/ul,上皮计数:67/ul.;尿液沉渣涂片见下图(10*40,未染色)最可能是:

答案:(颗粒管型/粗颗粒管型)
解析:颗粒管型(granular cast):管型中的颗粒占管型面积的1/3以上时称为颗粒管型。颗粒管型来自于崩解变性的细胞残渣、血浆蛋白及其他物质。颗粒管型外形常较透明管型短而宽大,容易折裂,可有不规则的断端,呈无色、淡黄褐色或棕黑色,其颗粒轮廓清晰。按颗粒的粗细又分为粗颗粒管型和细颗粒管型2种。前者充满粗大颗粒,常呈暗褐色,后者含许多微细颗粒,不透明,呈灰色或微黄色。
健康人尿液中一般颗粒管型,在激烈运动后、脱水和发热时可偶见细颗粒管型。颗粒管型的增多提示肾脏有实质性病变,如急性或慢性肾小球肾炎、肾病综合征、肾小管硬化症、慢性肾盂肾炎等。有急性肾衰竭的早期尿液中可有大量颗粒管型。慢性肾炎晚期出现颗粒管型时提示预后不良。颗粒管型与透明管型常同时出现,多见于急性或慢性肾小球肾炎、肾病综合径、肾小管硬化症、慢性肾盂肾炎、严重感染及肾动脉硬化。(临床检验基础 人民卫生出版社 第五版 主编 刘成玉 罗春丽 P176)
4、马XX 男70岁 主诉多饮、多尿、多食、体重下降1月;尿液常规检查:GLU:+-,BLD:3+,LEU:-,PRO:3+,NIT:-,URO:-,BIL:-,KET:-,PH:5.00,SG:1.020,颜色:无色,浊度:清亮;红细胞计数:6/ul,白细胞计数:12/ul,结晶计数:100/ul,管型:0/ul,上皮计数:1/ul.;结合病史下图(10*40,未染色)最可能是:

答案:(吞噬细胞/巨噬细胞)
解析:吞噬细胞(phagocyte)可分为小吞噬细胞和大吞噬细胞。前者来自中性粒细胞,多吞噬细菌等小物体。后者来自单核细胞称为巨噬细胞。巨噬细胞体积约为白细胞的2~3倍,一般为圆形或椭圆形,边缘不整;包核呈肾形或类圆形,结构细致,稍偏位;胞质丰富,胞质中有吞噬的物体很多,如红细胞、白细胞碎片、脂肪滴、精子、颗粒状物质以及其他不易识别的成分。有时胞质还可见空泡及伸出阿米巴样伪足,新鲜尿液中还可以见到伪足的活动。
参考区间:无吞噬细胞。
临床意义:尿液吞噬细胞可见于泌尿系统急性炎症,如急性肾盂肾炎、膀胱炎、尿道炎等,并伴有脓细胞和细菌。尿液吞噬细胞数量常与炎症程度有密切关系。
(临床检验基础 人民卫生出版社 第五版 主编 刘成玉 罗春丽 P172-173)
5、马XX 主诉:发热3天,,血常规检查:WBC:9.89(N:8.09L:N%:81.80L:0.52%:5.30%),RBC:4.28 HB127PLT:204,脑脊液培养细菌涂片及血平板培养如下图5-1/2,下图5-3(10*100,革兰染色)最可能的细菌是:

答案:(产单核细胞李斯特菌)
解析:1、基本特性:(1)形态结构:革兰阳性矮小杆菌,约为(1-2)umX(0.4-0.5)um,直或微弯,常呈V形双排列,偶尔可见双球状。(2)培养特性:本菌为兼性厌氧菌,营养要求不高,在普通培养基上能生长,但在含有血液、血清、腹水等培养基上生长更好。在3-45摄氏度均能生长,最适生长温度为30-37摄氏度。由于其在4摄氏度能生长,故可以冷增菌。在血琼脂平板上于18-24小时培养,形成较小、圆形、光滑而有狭窄β溶血环的菌落,往往把菌落刮去才可见菌落下面的β溶血环。
2、实验检查:鉴定:本菌特征是革兰阳性短杆菌,菌落较小,有狭窄窄β溶血环, 25摄氏度有动力,37摄氏度无动力或缓慢。触酶阳性,CAMP试验阳性,分解葡萄糖、水杨苷,水解七叶苷。
临床意义:产单核细胞李斯特菌广泛分布于自然界,水、土壤、人和动物粪便中均存在,常伴随EB病毒引起传染单核细胞增多症,也可以引起脑膜炎,菌血症等。
健康带菌者是本病的主要传染源,传播途径主要为:粪-口传播,也可以通过胎盘和产道感染新生儿;与患畜接触可接触眼和皮肤局部感染。
感染物质主要是溶血素和菌体表面成分。是典型的胞内寄生菌,机体主要靠细胞免疫清除菌。(临床微生物学检验 人民卫生出版社 第5版 主编 倪语星 尚红 P196-197)
感谢:重医大附一院检验科和石柱县人民医院提供的内容。


